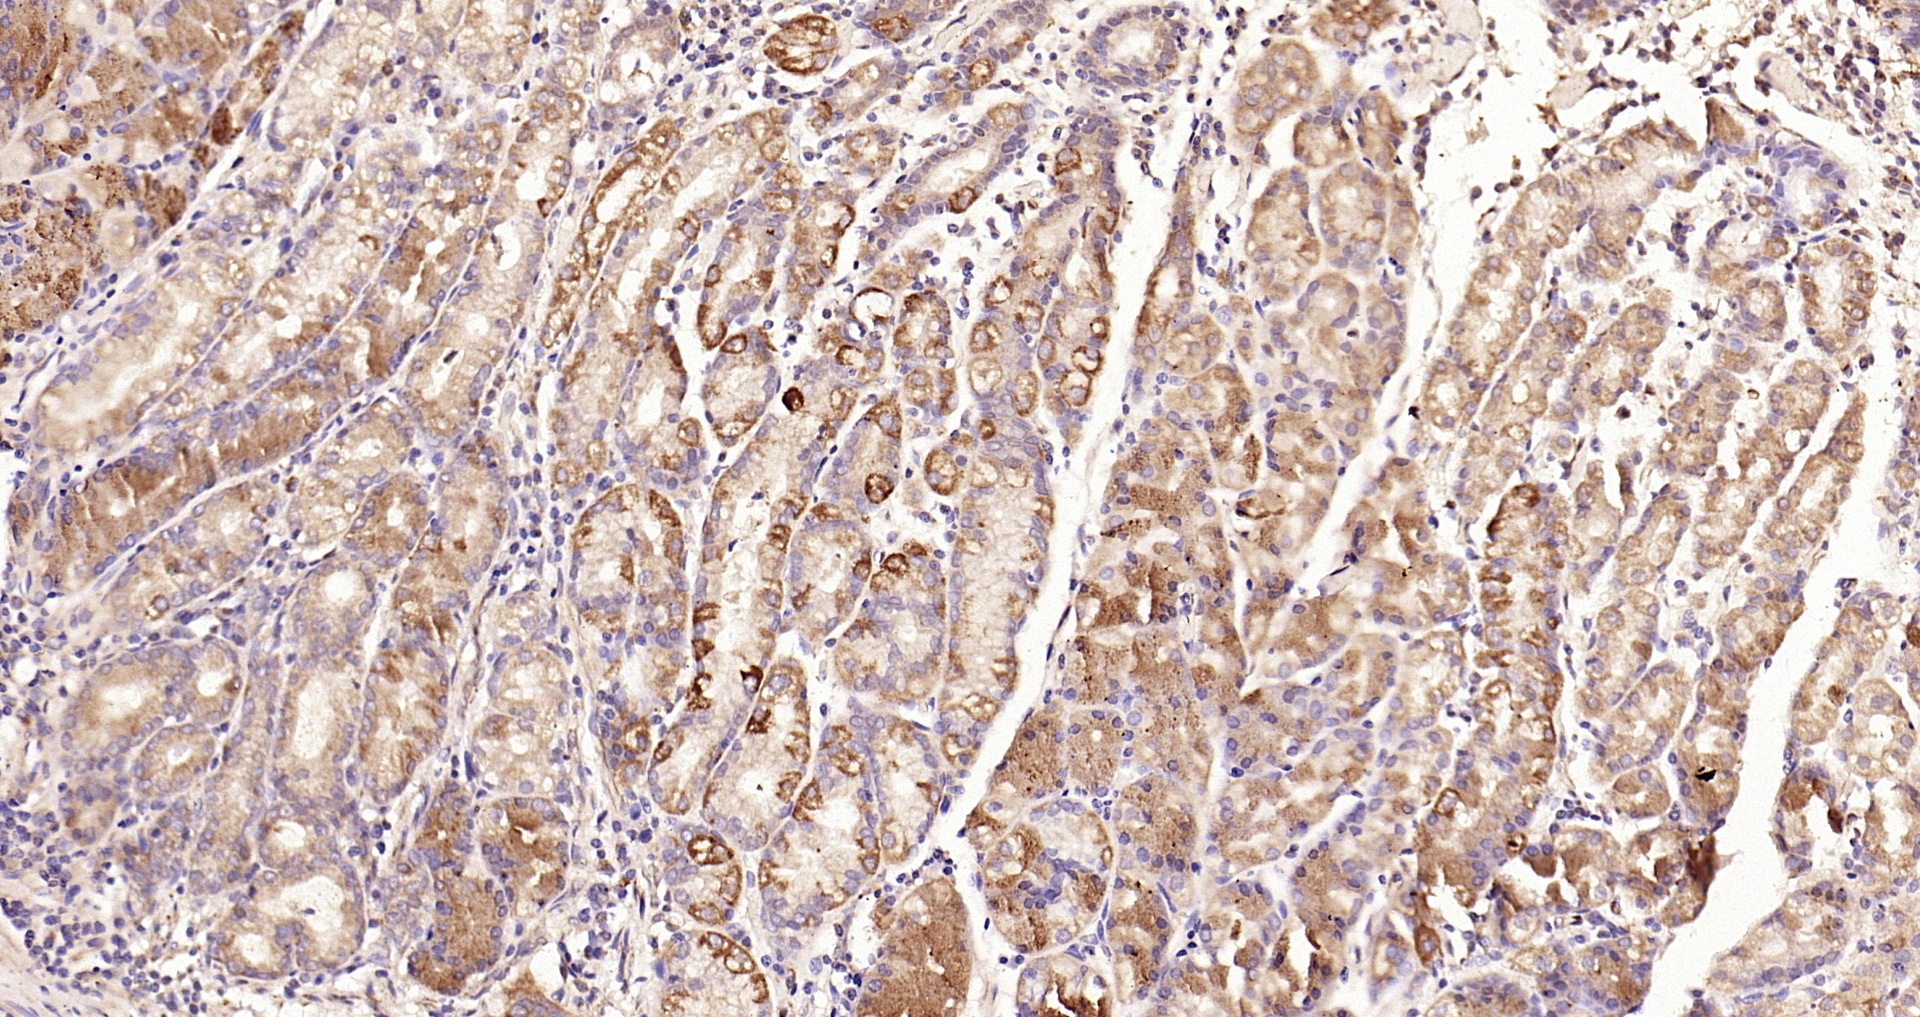
Paraformaldehyde-fixed, paraffin embedded Human gastric carcinoma; Antigen retrieval by boiling in sodium citrate buffer (pH6.0) for 15min; Block endogenous peroxidase by 3% hydrogen peroxide for 20 minutes; Blocking buffer (normal goat serum) at 37°C for 30min; Antibody incubation with TSSC3 Polyclonal Antibody, Unconjugated (bs-6884R) at 1:200 overnight at 4°C, DAB staining. Paraformaldehyde-fixed, paraffin embedded Human gastric carcinoma; Antigen retrieval by boiling in sodium citrate buffer (pH6.0) for 15min; Block endogenous peroxidase by 3% hydrogen peroxide for 20 minutes; Blocking buffer (normal goat serum) at 37°C for 30min; Antibody incubation with TSSC3 Polyclonal Antibody, Unconjugated (bs-6884R) at 1:200 overnight at 4°C, DAB staining.

Paraformaldehyde-fixed, paraffin embedded Rat stomach; Antigen retrieval by boiling in sodium citrate buffer (pH6.0) for 15min; Block endogenous peroxidase by 3% hydrogen peroxide for 20 minutes; Blocking buffer (normal goat serum) at 37°C for 30min; Antibody incubation with TSSC3 Polyclonal Antibody, Unconjugated (bs-6884R) at 1:200 overnight at 4°C, DAB staining.
TSSC3 Polyclonal Antibody
BS-6884R
ApplicationsImmunoFluorescence, Western Blot, ELISA, ImmunoCytoChemistry, ImmunoHistoChemistry, ImmunoHistoChemistry Frozen, ImmunoHistoChemistry Paraffin
Product group Antibodies
ReactivityBovine, Chicken, Equine, Human, Mouse, Porcine, Rat
TargetPHLDA2
Overview
- SupplierBioss
- Product NameTSSC3 Polyclonal Antibody
- Delivery Days Customer16
- ApplicationsImmunoFluorescence, Western Blot, ELISA, ImmunoCytoChemistry, ImmunoHistoChemistry, ImmunoHistoChemistry Frozen, ImmunoHistoChemistry Paraffin
- Applications SupplierWB(1:300-5000), ELISA(1:500-1000), IHC-P(1:200-400), IHC-F(1:100-500), IF(IHC-P)(1:50-200), IF(IHC-F)(1:50-200), IF(ICC)(1:50-200)
- CertificationResearch Use Only
- ClonalityPolyclonal
- Concentration1 ug/ul
- ConjugateUnconjugated
- Gene ID7262
- Target namePHLDA2
- Target descriptionpleckstrin homology like domain family A member 2
- Target synonymsBRW1C, BWR1C, HLDA2, IPL, TSSC3, pleckstrin homology-like domain family A member 2, beckwith-Wiedemann syndrome chromosomal region 1 candidate gene C protein, imprinted in placenta and liver protein, p17-BWR1C, p17-Beckwith-Wiedemann region 1 C, p17-Beckwith-Wiedemann region 1C, tumor suppressing subchromosomal transferable fragment cDNA 3, tumor suppressing subtransferable candidate 3, tumor-suppressing subchromosomal transferable fragment candidate gene 3 protein, tumor-supressing STF cDNA 3
- HostRabbit
- IsotypeIgG
- Protein IDQ53GA4
- Protein NamePleckstrin homology-like domain family A member 2
- ReactivityBovine, Chicken, Equine, Human, Mouse, Porcine, Rat
- Storage Instruction-20°C
- UNSPSC12352203
References
- Dong J, Wen L, Guo X, et al. The increased expression of glucose transporters in human full-term placentas from assisted reproductive technology without changes of mTOR signaling. Placenta. 2019,86:4-10. doi: 10.1016/j.placenta.2019.08.087Read this paper